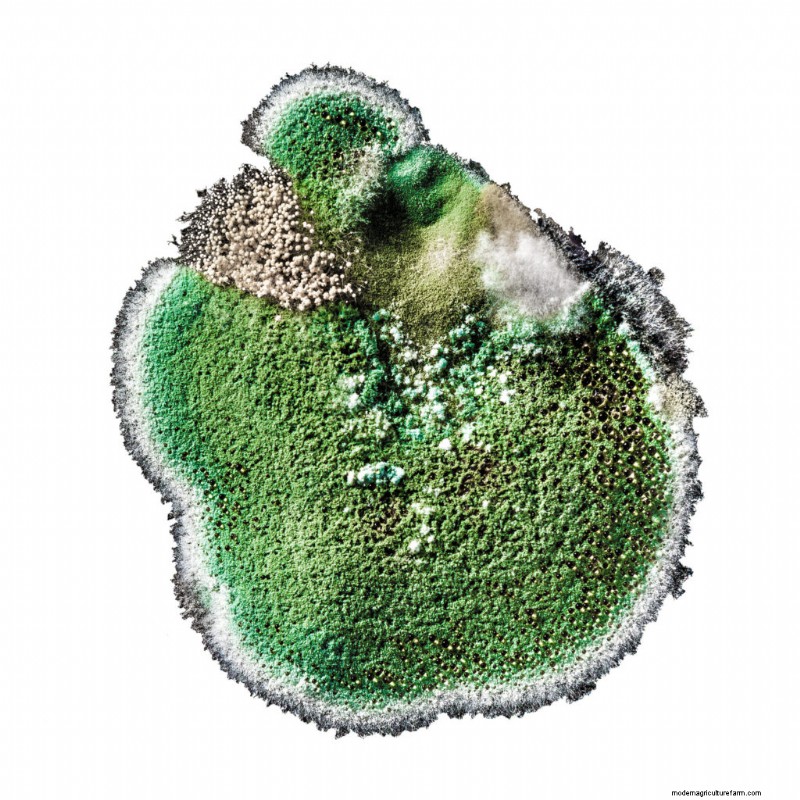

Congratulations! The precious seeds that you have sown with care have finally sprouted.
But on closer inspection, you notice there’s something else growing in your seedling trays, too.
Before you pat yourself on the back for a job well done, you should probably determine what the slimy green stuff actually is.
Your seedling soil can be covered with either green mold or algae, a common type of moss-like plants that thrive in warm, humid conditions. Your seeding room or greenhouse may be an ideal environment for algae to grow if you’re overwatering the plants in a room with little airflow.
Green mold isn’t a death threat for your seedlings, but its presence signals the existence of another, more sinister pest. Read on to learn what green mold is, what it might mean for your seedlings, and how to eliminate it.
Green mold thrives in warm, humid conditions. Seedlings need water, light, heat, and fertilizer – but applying these things too often or too soon will create an environment ripe for algae and other fungal growth.
Algae prefer some growing mediums over others – if you’re using potting soil high in organic content or a soil block mix high in peat moss, you might be more likely to see algae as these mediums hold excess moisture and nutrients.
Green mold doesn’t directly harm seedlings, but it may cause problems when it competes with plants for space, nutrients, and water. If left untreated, green mold will take over seedling trays and create a crusty barrier, making it harder for plants to absorb the water and nutrients they need.
What’s more damaging than algae growth is the humid environment that supports it. When you see algae develop on your seedling trays, take steps to adjust the climate to one that is much better suited for your seedlings.
A little extra preparation before you even begin to sow seeds will make a world of difference in the success of the season. What follows are tried-and-true methods to prevent the growth of green mold and tips for managing existing populations.
At the end of the growing season, take inventory of what pots and flats you have on hand. Rinse with a diluted bleach solution (1 part bleach to 9 parts water) and allow to air dry before you stack them.
By properly sanitizing trays at the end of the year, you will ensure that no mold spores or diseases live through the winter to infect next season’s seedlings.
Invest in a quality seed-starting mix to use for seed sowing. While it’s more expensive to buy name-brand mixes, you’ll save yourself future frustrations by doing so.
Make sure to buy seed-starting mix and not generic potting soil. Potting soil is made for mature plants – it contains higher percentages of compost and organic matter. These nutrient-dense mixes are ideal for sprouting algae and other unwanted organisms.
Heat mats are wonderful tools for quick seed germination, but if you keep a tray of seedlings on heat too long, you open up a window of opportunity for green mold to grow.
As soon as your seedlings pop up, remove that tray from its heat mat. Be sure to take the lids off, too, as they are no longer needed.
Seedlings need 12-16 hours of light per day – any more than that and you run the risk of incubating algae populations. Any less than 12 hours and you will have slow-growing seedlings that can’t outcompete green mold.
Once seedlings have their first true leaves they will begin to shade out the algae underneath them, and the green mold will eventually die back.
Overwatering is the primary reason that seedling trays will start showing green mold. If you change up your watering schedule slightly you can create an environment where green mold can’t survive.
Scale back on watering seedlings from every day to a few times a week. Be sure to let the soil blocks or cells dry out completely between waterings.
Make it a habit to water in the morning instead of the evening.
If overhead watering, be sure that bottom trays have good drainage.
You can also opt to bottom water instead of overhead water. To do this, nest the seedling tray inside another tray without holes. Fill the bottom tray with an inch of water and let the seedling tray absorb water from the bottom up. After thirty minutes dump any excess water.
Be cautious of self-watering trays. These systems do have their uses, but as they are designed to create a continuously moist environment they may actually invite the growth of green mold.
Ventilate your greenhouse by rolling up the sidewalls and doors. If your seedling room is inside, throw open a window and allow some of that humidity to dissipate.
You can also increase airflow by using a fan. Oscillating fans work particularly well as the fan moves, sending air in all directions–but box fans and ceiling fans will also do.
Put the fan on a timer or just turn it on for a few hours during the hottest part of the day.
Use the lowest setting or keep the fan a good distance from your seedlings – gentle airflow will strengthen the tiny stems, but a powerful fan placed too close could do more harm than good.
If you have an excessively humid space, you might consider using a dehumidifier to manage humidity levels. Many dehumidifiers can be programmed to reach an ideal level before shutting down.
Be mindful of your watering schedule when using a fan or a dehumidifier – both will cause the soil to dry out more quickly. Be sure that you aren’t letting your seedling trays get too dry between waterings.
Thinning seedlings is another method to increase air circulation at the base of the plant.
Removing plants from an overcrowded cell allows the remaining seedlings to develop stronger root systems. These healthier starts will be better suited to compete with green mold for sunlight and water.
If you can’t stomach the idea of throwing out these extra seedlings, pot them up or enjoy the young spouts as microgreens in your lunch salad!
Organic fertilizer is crucial to growing healthy plant starts. However, fertilizers should be applied to the soil only after seedlings have grown their first set of true leaves.
Fertilizers contain minerals and nutrients that young plants need, but seedlings cannot digest these compounds until they are older. If you apply fertilizer too soon, all you will accomplish is feeding the green mold.
Stay away from fertilizer and compost until your seedlings are at or past the cotyledon stage.
Some gardeners treat green mold with cinnamon, a natural antifungal. Dusting the soil around your plants with cinnamon may kill off green mold and mildew.
Cinnamon can also be applied as a spray: mix ground cinnamon and warm water together, let steep for several hours and strain the larger particles out with a cheesecloth. Spray liquid directly onto the soil.
Green mold does not like to be disturbed, so aerating the soil around your seedlings is an effective way to slow its spread. Put on gloves and scratch algae away with your hand or a tool.
Bumping up your seedlings to bigger pots will also accomplish this purpose.
Wait until your seedlings have at least one set of true leaves, or until the root begins to reach for the bottom of the cell.
Start prepping the new pots or trays by filling them halfway with soil. Using a butter knife, pop the plug out from the tray, and gently transfer it to a bigger pot. Loosen the roots and begin filling in the bigger pot with soil. Fill up to the soil line and then a little more, to cover any existing algae.
When green mold starts growing on your seedling flats, it’s a sign that the growing conditions aren’t right for your plants.
The presence of algae is a sign that the area is too humid. And while humidity itself won’t kill your plants, something else will.
Damping off happens suddenly, seemingly overnight. Your seedlings will look healthy one day, and the next morning they will have toppled over. The stem will be mushy and weak, unable to support the weight of the plant.
Damping off is the result of a fungus infestation that thrives in the same conditions that produce green mold. The fungus can be spread via seedling trays, tools, hands, and irrigation systems.
To avoid future battles with damping off, look for seeds that are treated with a fungicide.
Protect your current seedlings from damping off by applying diluted fungicide as a soil amendment, a mist, or a drench.
While green mold itself isn’t particularly dangerous, its presence is an indicator that growing conditions aren’t quite right for your seedlings
The best way to fight green mold is to prevent it from growing in the first place, by sterilizing seedling trays, using quality seed-starting mix, and monitoring water and humidity levels closely.
If you maintain ideal growing conditions for your seedlings, green mold will never develop and you won’t need to worry about your seedlings damping off.